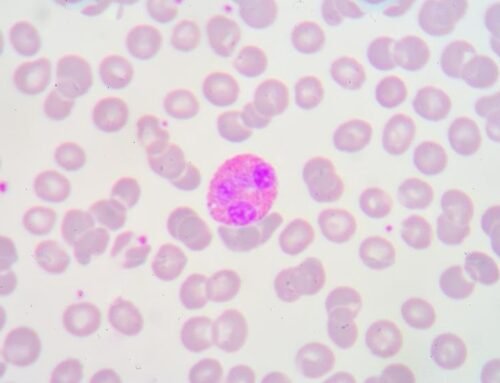
Eozinofilik kolit teşhisi nasıl konulur?

Eozinofilik kolit, besin alerjisinde bağlı eozinofilik enflamasyonun kalın bağırsak kısmının tutulduğu besin alerjisine denilmektedir. Bebeklikten yetişkin yaşa kadar her yaşta görülebilmekle birlikte bebeklerde daha sıktır. Besin alerjisine bağlı enterolit sendromuna benzer. Diğer eozinofilik mide bağırsak tutulumlarına göre daha ağır bir seyir göstermektedir. Tam olarak neden bilinmemektedir. Sıklıkla diğer alerjik hastalıklar olan çocuk ve yetişkinlerde görülmektedir.